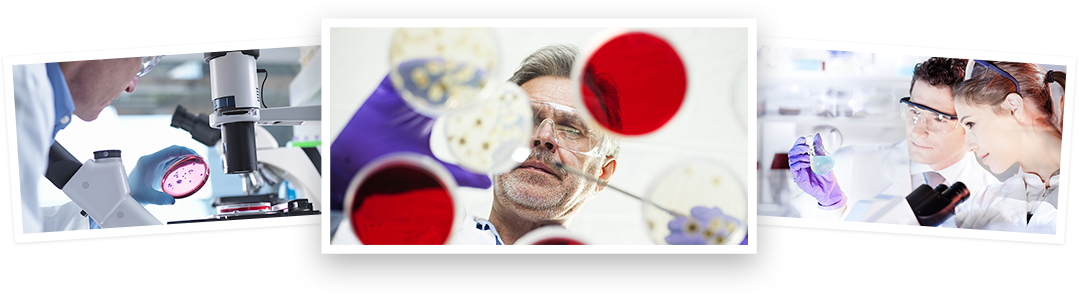

依科賽生物(ExCell Bio)創立于2013年,以“加快生命科技應用,造福百姓健康”為使命,致力于解決生物醫藥卡脖子、實現關鍵原料國產化,現已成為中國生物醫藥上游核心原材料的領軍企業之一。公司是國家高新技術企業,國家級專精特新小巨人企業,中國首家國際血清行業協會(ISIA)會員單位,江蘇省生物制藥、細胞治療等領域用CD無血清培養基工程研究中心。
覆蓋各大領域、用優質產品+前沿技術+貼心服務打造整體解決方案
為生命科研工作者和人類健康提供優質的產品和服務

依科賽生物(ExCell Bio)創立于2013年,以“加快生命科技應用,造福百姓健康”為使命,致力于解決生物醫藥卡脖子、實現關鍵原料國產化,現已成為中國生物醫藥上游核心原材料的領軍企業之一。公司是國家高新技術企業,國家級專精特新小巨人企業,中國首家國際血清行業協會(ISIA)會員單位,江蘇省生物制藥、細胞治療等領域用CD無血清培養基工程研究中心。

江蘇省外國專家工作室

江蘇省企業技術中心

2019年度科技人才先進企業

高新技術企業

制造業提升先進企業

血清達標企業證書

生物協會會員單位

血清達標合格證書

ISO證書